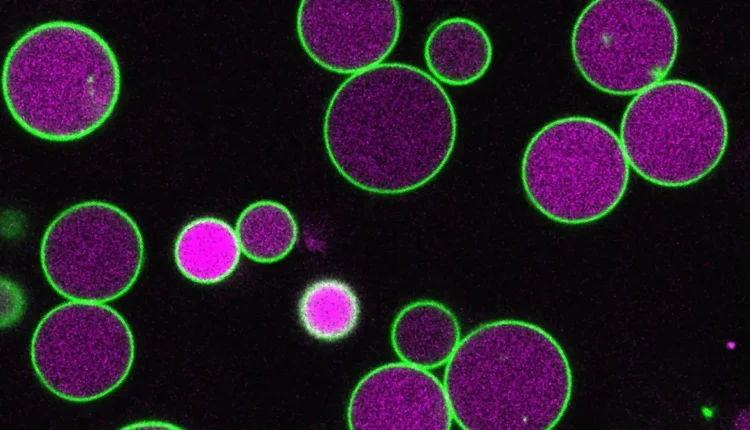

Οι επιστήμονες ανακάλυψαν τι εμποδίζει τα φυτικά κύτταρα από το να αναπτύσσονται ανεξέλεγκτα
Αυτή η εικόνα δείχνει τα διογκωμένα περοξισώματα που στερούνται κυψελών, τα οποία προκύπτουν όταν δύο γονίδια PEX11 είναι μη λειτουργικά. Είναι ένα συνεστραμμένο μικροσκόπιο με τις μεμβράνες (πράσινο) και το εσωτερικό (ματζέντα) των περοξισωμάτων να επισημαίνονται με διαφορετικές φθορίζουσες πρωτεΐνες. Πίστωση: Nathan Tharp/Rice University
Τα φυτά περνούν το μεγαλύτερο μέρος της ζωής τους χρησιμοποιώντας τη φωτοσύνθεση για να παράγουν ενέργεια. Ωστόσο, στην πρώιμη φάση μετά την ανάπτυξη ενός σπόρου, δεν μπορούν ακόμη να συλλάβουν φως. Κατά τη διάρκεια αυτού του σύντομου αλλά κρίσιμου παραθύρου, βασίζονται αντ’ αυτού σε αποθηκευμένα λιπαρά οξέα. Για να διασπάσουν αυτά τα λιπαρά οξέα, τα φυτικά κύτταρα χρησιμοποιούν μια εξειδικευμένη δομή γνωστή ως περοξισώμα, ένα διαμέρισμα που περιβάλλεται από μεμβράνη και βρίσκεται επίσης σε ανθρώπινα κύτταρα. Λόγω του μεγέθους και της ορατότητάς τους, τα φυτικά κύτταρα χρησιμεύουν ως ένα χρήσιμο σύστημα για τη μελέτη του τρόπου λειτουργίας των περοξισωμάτων.
“Το φυτό που χρησιμοποιούμε, η Arabidopsis, έχει μεγάλα κύτταρα και περοξισώματα τόσο μεγάλα που μπορούμε να τα δούμε στο εσωτερικό τους με ένα μικροσκόπιο φωτός”, δήλωσε η Bonnie Bartel, Καθηγήτρια Βιοεπιστημών Ralph και Dorothy Looney. “Το περοξισώμα γίνεται ακόμη μεγαλύτερο κατά τη διάρκεια της φάσης σπόρου προς φυτό, όταν το φυτό βασίζεται σε λιπαρά οξέα για ενέργεια, πριν συρρικνωθεί ξανά στο κανονικό του μέγεθος μόλις το φυτό μπορεί να φωτοσυνθέσει.”
Η πρωτεΐνη PEX11 βοηθά στον έλεγχο του μεγέθους του περοξισώματος
Η ομάδα του Bartel επικεντρώνεται σε αυτά τα διογκωμένα περοξισώματα, ιδίως σε μια πρωτεΐνη που ονομάζεται PEX11. Οι επιστήμονες γνώριζαν από καιρό ότι η PEX11 παίζει ρόλο στο να βοηθά τα περοξισώματα να διαιρούνται. Σε νέα έρευνα που δημοσιεύθηκε στο Nature Communications, η ομάδα διαπίστωσε ότι αυτή η πρωτεΐνη βοηθά επίσης στον έλεγχο του πώς τα περοξισώματα επεκτείνονται και συρρικνώνονται κατά την πρώιμη ανάπτυξη των φυτών.
“Τα περοξισώματα εμπλέκονται σε ορισμένες ανθρώπινες ασθένειες και χρησιμοποιούνται στη βιομηχανική μηχανική”, δήλωσε ο Nathan Tharp, πρώτος συγγραφέας της εργασίας και μεταπτυχιακός φοιτητής του Rice. “Ωστόσο, μπορεί να είναι κάπως δύσκολο να μελετηθούν.”
Χρήση CRISPR για τη μελέτη μιας σύνθετης πρωτεΐνης
Μια κοινή στρατηγική για την κατανόηση μιας πρωτεΐνης είναι η απενεργοποίηση του γονιδίου που είναι υπεύθυνο για την παραγωγή της και η παρατήρηση των επιπτώσεων. Σε αυτή την περίπτωση, η κατάσταση ήταν πιο περίπλοκη. Η PEX11 παράγεται από πέντε διαφορετικά γονίδια. Η διακοπή μόνο ενός από αυτά είχε μικρή επίδραση, αλλά η αφαίρεση και των πέντε προκάλεσε τον θάνατο του φυτού. Αυτό κατέστησε δύσκολο τον εντοπισμό της λειτουργίας της πρωτεΐνης.
Για να ξεπεράσει αυτό το πρόβλημα, ο Tharp χρησιμοποίησε προηγμένες τεχνικές CRISPR για να απενεργοποιήσει επιλεκτικά διαφορετικούς συνδυασμούς των πέντε γονιδίων.
“Ήμουν σε θέση να χρησιμοποιήσω τις πρόσφατες εξελίξεις στο CRISPR για να πάω και να σπάσω συγκεκριμένους συνδυασμούς των πέντε γονιδίων”, δήλωσε ο Tharp, ο οποίος πρόσφατα υπερασπίστηκε τη διατριβή του. “Μόνο τότε καταφέραμε να δούμε ότι η PEX11 εμπλέκεται σαφώς στον έλεγχο της ανάπτυξης του περοξισώματος κατά τη φάση σπόρου προς φυτό.”
Γιγάντια περοξισώματα αποκαλύπτουν μηχανισμό ελέγχου ανάπτυξης
Ο Tharp μηχανικά δύο τύπους μεταλλαγμένων φυτών, καθένα από τα οποία έλειπε ένα συγκεκριμένο σύνολο γονιδίων PEX11. Και στις δύο περιπτώσεις, τα περοξισώματα επεκτάθηκαν κατά τη φάση σπόρου προς φυτό όπως αναμενόταν. Ωστόσο, αντί να συρρικνωθούν στο συνηθισμένο τους μέγεθος, κάποια συνέχισαν να μεγαλώνουν πολύ πέρα από τα φυσιολογικά όρια. Σε ακραίες περιπτώσεις, τα περοξισώματα επεκτάθηκαν από το ένα άκρο του κυττάρου στο άλλο.
Αυτά τα μεταλλαγμένα κύτταρα έλειπαν επίσης κυψέλες, μικρά διαμερίσματα που περιβάλλονται από μεμβράνη, τα οποία συνήθως σχηματίζονται μέσα στο περοξισώμα κατά την επεξεργασία λιπαρών οξέων. Υπό κανονικές συνθήκες, αυτές οι κυψέλες αναπτύσσονται καθώς το περοξισώμα μεγαλώνει και φαίνεται να αφαιρούν τμήματα της εξωτερικής του μεμβράνης.
“Οι κυψέλες που παίρνουν κομμάτια μεμβράνης καθώς σχηματίζονται μπορεί να βοηθούν στον έλεγχο της ανάπτυξης του περοξισώματος”, δήλωσε ο Tharp. “Στα μεταλλαγμένα μας PEX11, αυτές οι κυψέλες είτε δεν σχηματίζονται είτε είναι αφύσικα μικρές και σπάνιες, και έτσι βλέπουμε αυτά τα τεράστια περοξισώματα, πολύ μεγαλύτερα από το κανονικό.”
Τα ευρήματα επεκτείνονται πέρα από τα φυτά σε άλλα είδη
Αν και η έρευνα επικεντρώθηκε στα φυτά, ο Tharp ήθελε να μάθει αν ο ίδιος μηχανισμός μπορεί να υπάρχει και σε άλλους οργανισμούς. Για να δοκιμάσει αυτή την ιδέα, εισήγαγε την εκδοχή της πρωτεΐνης από ζύμη, που ονομάζεται Pex11, στα μεταλλαγμένα φυτικά κύτταρα.
“Βάλαμε την Pex11 της ζύμης στα μεταλλαγμένα φυτικά μας κύτταρα για να δούμε αν θα μπορούσε να επιστρέψει τα περοξισώματα στο φυσιολογικό”, δήλωσε ο Tharp. “Και το έκανε.”
Αυτό το αποτέλεσμα υποδηλώνει ότι η Pex11 εξυπηρετεί μια παρόμοια λειτουργία στη ζύμη όπως και στα φυτά, παρά την τεράστια εξελικτική απόσταση μεταξύ τους. Λόγω αυτού, η πρωτεΐνη μπορεί επίσης να παίζει ρόλο σε άλλα είδη κυττάρων, συμπεριλαμβανομένων των ανθρώπινων κυττάρων.
“Το εύρημα ότι αυτή η πρωτεΐνη εκπληρώνει τον ίδιο ρόλο σε κύτταρα ζύμης και φυτών υποδηλώνει ότι μπορεί να είναι μια πολύ διατηρημένη πρωτεΐνη”, δήλωσε η Bartel. “Τα ευρήματά μας στα φυτά, σε αυτό το σχετικά εύκολο να μελετηθεί πρότυπο, μπορεί έτσι να είναι εφαρμόσιμα σε ανθρώπινα κύτταρα και σε κύτταρα που χρησιμοποιούνται για βιομηχανική μηχανική.”
